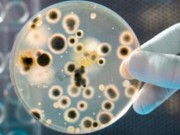
Sức khỏe - Thiết bị phát hiện vi khuẩn sinh sôi trong thực phẩm

Sưng viêm mạn tính là yếu tố đe dọa thường trực cho sức khỏe, gây đau đớn, khó chịu và bệnh tật, từ đột quỵ, tiểu đường đến đau khớp.
Dù bạn có thể dùng thuốc giảm đau tạm thời nhưng nguyên nhân gây sưng viêm phần nhiều lại có sự đóng góp của chế độ ăn. Khi bị đau, sưng viêm, bạn nên cắt bớt những thực phẩm sau.
Kiêng các món như gà chiên, cá chiên, khoai tây chiên... trong thời kỳ sưng viêm cũng giúp cho tình trạng sưng viêm giảm rõ. Hình minh họa.
1. Khoai tây chiên: Bạn cũng nên tránh các món như cá chiên, gà chiên... Nghiên cứu cho thấy rằng khi giảm ăn thức ăn chiên, tình trạng sưng viêm trong cơ thể cũng giảm xuống.
2. Bánh mì trắng: Thực phẩm chứa nhiều tinh bột chế biến có thể tạo ra các dấu hiệu gây sưng viêm. Bánh mì trắng chứa rất nhiều tinh bột tinh chế, do đó càng cần được hạn chế.
3. Kem uống với cà phê: Là thực phẩm có chứa nhiều chất béo chuyển hóa, thành phần chính kích hoạt sưng viêm. Các sản phẩm được phép ghi "Không chứa chất béo chuyển hóa" khi liều lượng của nó ở dưới nửa gram mỗi phần, do đó bạn vẫn có thể nạp nó vào mà không biết.
4. Bánh donut: Chứa tinh bột tinh chế cùng rất nhiều đường gây sưng viêm.
Rượu cũng là một nguyên nhân gây sưng viêm nặng hơn. Hình minh họa.
5. Ly rượu thứ hai: Vài nghiên cứu cho rằng uống một ít rượu có lợi cho sức khỏe. Nhưng nhiều hơn một ly có thể gây viêm nặng hơn, nhất là cho phụ nữ.
6. Bánh nướng: Loại bánh này chứa rất nhiều tinh bột chế biến, đường, chất béo chuyển hóa. Chúng còn có thể chứa các loại dầu như dầu đậu nành, dầu ngô chứa omega-6 gây sưng viêm.
7. Yến mạch làm sẵn: Một số sản phẩm yến mạch thì lành mạnh nhưng cũng có sản phẩm chứa nhiều phụ gia có hại.
8. Thịt xông khói: Loại thịt được chế biến sẵn này chứa nhiều chất béo bão hòa trong quá trình sản xuất, tương tự với hotdog, xúc xích…
9. Thanh kẹo ngũ cốc: Các sản phẩm được cho là "lành mạnh" cũng cần được chú ý, vì chúng có thể chứa nhiều đường.
Nếu bị sưng viêm, bạn cũng nên kiêng sữa chua có đường. Hình minh họa.
10. Sữa chua có đường: Các loại sữa chua chứa hương liệu này đều có lactose, là một loại đường trong sữa, ngoài ra chúng còn có thể chứa siro gạo nâu, mật đường… Các nhà sản xuất dùng nhiều loại đường khác nhau để chúng không xuất hiện chỉ số quá cao trong thành phần.